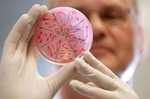

Мифы об инфекциях

Во многих переводах заграничных книг, посвященных будущим матерям, вопросы о«скрытых» инфекциях почти не затрагиваются, а если и затрагиваются, то упоминается лишь несколько опасных инфекционных заболеваний для будущей матери. Перелистав и просмотрев многие такие издания и те, которые не переведены на русский язык, у меня возник довольно забавный вопрос: неужели «заграничные» женщины отличаются чем-то по своему строению от «наших» женщин, коль их никто не запугивает «скрытыми» инфекциями, не посылает на сдачу огромного количества ТОРЧ-тестов, не вычищает их влагалище и весь организм якобы для профилактики заражения новорожденного страшными инфекциями, не требует сдавать посевы из носа не только их мужьям, но и самим женщинам? И много чего такого им не предлагается делать, через что проходит «наша» женщина, которой смело можно присвоить звание «матери-героини» за успешное хождение по мукам и страданиям через всю беременность и рождение долгожданного ребенка! Отчего же они вынашивают без особого страха, без мотания по кабинетам врачей и УЗИ-кабинетам, и рожают лучше, здоровее, с меньшим количеством осложнений? Потому что у них меньше стресса в жизни? Потому что у них лучше условия жизни? Нет, стресса у всех хватает, как и условия жизни у большинства не такие, какими вы видите в голливудских фильмах. Ответ здесь кроется в том, что этих женщин, действительно, никто не пугает невынашиваением беременности, страшными скрытыми инфекциями, и не назначает чуть ли не с первого и до последнего для беременности горы ненужных препаратов якобы для профилактики невынашивания беременности или лечения всяких несуществующих в большинстве случаев угроз прерываний беременности. Если лечение необходимо, то оно назначается осторожно, не без объяснения женщине, чем ей полезно лечение, а чем «грозит» нелечение.
Рассуждая об инфекциях, так и хочется крикнуть со всей силой, чтобы донеслось во все уголки той четверти земного шара, где об этом забыли или не знают: «не так страшен черт, как его малюют!» Не так страшны вирусы, бактерии, грибки, одноклеточные и другие микроорганизмы, как вам об этом говорят, как вы потом об этом говорите! Услышали? Если нет, пожалуйста, прочитайте предыдущие предложения снова.
Итак, давайте примем во внимание тот факт, что мы живем в окружающей среде, где в одном кубическом сантиметре (воздуха, почвы, воды и т. д.) может обитать от нескольких тысяч до несколько сот миллиардов микроорганизмов! Даже то, что мы называем стерильным, при соприкосновении с воздухом и другими предметами, перестает быть стерильным. Наш организм тоже не стерильный! Например, на коже обитает несколько видов различных вирусов, грибков, бактерий, что является нормой. В ротовой полости обитает более 100 видов микроорганизмов. Прямая кишка, где формируются каловые массы, содержит миллиарды бактерий и грибков, что и должно быть в норме. Во влагалище может обитать от нескольких до нескольких десятков видов микроорганизмов. Даже находясь в утробе матери, ребенок может заразиться ее вирусам и бактериями, и в большинстве случаев такое заражение для плода не опасно и протекает бессимптомно. С рождением, организм ребенка заселяется огромным количеством микроорганизмов очень быстро, потому что ребенок дышит тем же воздухом, что и вы, постепенно начинает принимать пищу, что и вы, и имеет контакт с окружающей средой, в которой вы тоже живете.
Если говорить о строении генетического материала человека, то есть о ДНК (дезоксирибонуклеиновая кислота) и РНК (рибонуклеиновая кислота), то он построен из тех же структурных ячеек, что и ДНК и РНК вирусов, бактерий, грибков и других живых организмов нашей планеты. Поэтому между нами и микроскопическими обитателями Земли есть определенное генетическое родство, и многие ученые утверждают, что 90% нашей генетической информации копирует генетическую (и генную в том числе) информацию тех живых существ, которые обитали и обитают во всех уголках земного шара.
Мы не будем вдаваться в подробности нашего родства с другими представителями живого мира, однако учтем тот факт, что если бы микроорганизмы были настолько опасны для человеческого организма, как об этом говорят некоторые люди, даже с медицинским образованием, то все люди на Земле вымерли бы давным-давно, еще до появления антибиотиков и прочих лекарств, и нас с вами сейчас не было бы. Вы бы не родились у своих родителей, которые антибиотиками и противовирусными препаратами, наверняка, не увлекались. Вы бы не выжили до того момента, когда вам хочется иметь собственных детей. Однако, постоянно убивая чуть ли не все микроорганизмы, живущие в вашем организме скрыто, вы разрушаете биологически-экологический баланс, созданный природой по своим законам, подавляете свою защитную систему, и открываете ворота для чужеродных внедрителей, или же вводите в состояние агрессивности и войны те группы микроорганизмов, которые уже существуют в вашем теле.
Естественно, существует ряд инфекционных заболеваний, которые необходимо лечить, иногда лечить срочно и агрессивно. Но по статистике, в дорожно-транспортных происшествиях, от врачебных ошибок, из-за последствий курения, переедания и малоподвижности современные люди гибнут чаще, чем от всех существующие ныне инфекционных заболеваний, в том числе таких опасных, как СПИД, гепатиты В и С и ряд других.
Если вы чувствуете себя здоровым человеком, у вас нет жалоб, то весьма маловероятно, что вашей будущей беременности и ребенку грозит какая-то опасность из-за скрытой инфекции. Если смотреть на отчеты ВОЗ об уровне материнской смертности, куда входит смерть беременных женщин и женщин послеродового периода, то причины смертности разделены в две категории: связанные непосредственно с беременностью и ее осложнениями, и не связанные с беременностью. Из более полумиллиона женщин, умирающих каждый год, только 1% случаев смерти выпадает на развитые страны, куда бывшие республики Советского Союза не вошли. В остальных странах, которые принято называть развивающимися, каждую минуту умирает женщина, беременная или родившая, что связывают с отсутствием качественной медицинской помощи в этих странах.
Согласно данным за 2005 год, в развивающихся странах, куда также вошли все постсоветские государства, причины смертности следующие: острое кровотечение – 25% случаев, инфекции – 15%, аборты – 13% случаев, эклампсия (судороги из-за высокого давления) – 12% случаев, патологические роды – 8%, другие причины, связанные с беременностью и родами – 8%, и причины, не связанные с беременностью и родами – 20% случаев. Акцентируя внимание на довольно большом проценте причин инфекционного происхождения (15%), кому-то наверняка захочется меня упрекнуть: «Вот вам и скрытые инфекции! Как же с ними не бороться?». Но я разочарую сторонников агрессивной борьбы со «скрытыми» инфекциями, уточнив, что в данной категории основные причины смертности составляют воспаления внутренней оболочки матки – септические бактериальные эндометриты (после прерывания беременности и родов) из-за антисанитарии тех условий, в которых прерывают беременности и рожают детей, а также из-за распространенного среди африканского населения большого количества случаев инфицирования ВИЧ инфекцией и СПИДа. Таким образом, доля «скрытых» инфекций, которых так боятся наши женщины и лечат агрессивно месяцами наши врачи, на самом деле очень мизерная, и не заслуживает особого внимания.
«Хорошо, для матери скрытые инфекции, может, и не так страшны. Но ведь из-за них гибнут плоды и умирают новорожденные!» – скажет оппонент. Давайте посмотрим на данные ВОЗ. Перинатальная смертность включает в себя случаи мертворождения и случаи смерти новорожденных возрастом до 28 дней. В России, Белоруссии и на Украине, которые вошли в группу стран восточной Европы, уровень мертворождаемости в 5 раз больше и уровень смертности новорожденных в 2 раза больше, чем в странах центральной и западной Европы, США и Канады, где борьбу со скрытыми инфекциями у беременных женщин никто из врачей не ведет, и не назначает женщине противовирусные препараты и в придачу еще целый арсенал «для усиления воздействия» основного лечения. Во всем мире 3.3 млн. детей рождаются мертвыми, а 4 млн. новорожденных умирает в первый месяц жизни (первые 28 дней). Только 2% новорожденных умирает в развитых странах. Повторю снова: в развитых странах женщин скрытыми инфекциями не «терроризируют».
Каковы причины смертности? Преждевременные роды и недоношенность составляют 28% причин детской (неонатальной) смертности, однако речь идет не об инфекциях, которые привели к преждевременным родам, а о таких осложнениях беременности, как гипертоническая болезнь, преэклампсия, плацентарная недостаточность и ряд других проблем; 8% новорожденных умирает из-за врожденных пороков развития, 7% – из-за столбняка (очень распространенная инфекция в развивающихся странах), 26% – из-за острой выраженной инфекции, когда инфицирование происходит в ходе родов и первые дни после родов (90% случаев заражений составляют случаи малярии, ВИЧ-инфицирования, воспаления легких (пневмония), кори); диарея (поносы), вызванная неправильным питанием, и пищевое истощение являются причиной смерти в 3% случаев, удушье (асфиксия) в родах – 23% случаев (в развитых странах асфиксия в родах встречается не часто), 7% новорожденных умирает по другим причинам. Таким образом, даже в самых бедных странах единственная скрытая инфекция, которая передается от матери новорожденному, а не плоду, и на которую обращено внимание врачей, является ВИЧ-инфекция. Но России и Украине, да и другим постсоветским странам, до уровня заражения этим видом инфекции африканского населения пока что далеко. А что же мешает им улучшить (уменьшить) показатели смертности и быть наравне с большинством европейских стран, а также США и Канады? Отсутствие современной высококачественной профессиональной системы здравоохранения, и, естественно, хорошо подготовленных медицинских кадров.
Я часто получаю письма отчаявшихся женщин, которые до похода в женскую консультацию или поликлинику, не знали, что они заражены «страшными» вирусами герпеса, цитомегаловируса или папиллома вируса, а теперь не знают, как дальше жить с такими «опасными инфекциями»,
Во-первых, вы должны понимать, что все микроорганизмы обитают в определенных частях нашего тела, поэтому некоторые из них отношения к репродуктивной системе не имеют, на зачатие не влияют, как и на вынашивание потомства тоже, хотя могут быть опасными для новорожденного, если в период родов у матери, например, имеется активный инфекционный процесс.
Во-вторых, все микроорганизмы, которые обитают на поверхности и внутри нашего тела, можно разделить на вирусы, бактерии, грибки, протозойные одноклеточные и промежуточные формы (например, уреаплазма, микоплазма, которые могут иметь свойства и вирусов, и бактерий).
В-третьих, попав в человеческий организм, большинство микроорганизмов оккупируют ту часть тела, тканей, клеток, где самые благоприятные условия для их жизни, без вреда для человека, не вызывая симптоматики, и создавая симбиоз (то есть, сожительство) с организмом человека и его другими обитателями.
Теперь разберемся с определением «скрытые инфекции». Что такое скрытые инфекции? Некоторые скажут, что это те инфекции, которыми человек заражен, но он об этом не знает, и в определенные моменты жизни они могут проявляться серьезными заболеваниями. Другие скажут, что в отношении женщины и беременности, это те инфекции, которые могут повредить плод и даже привести к его гибели. Третьи тут же напомнят о ТОРЧ-инфекциях, но большинство не знает, что такое «ТОРЧ», какие инфекции входят в понятие «ТОРЧ», как часто необходимо делать ТОРЧ-тест.
Возвращаясь к определению скрытых инфекций, я вас спрошу: а разве не все микроорганизмы живут скрыто в человеческом организме и человек видеть их невооруженным глазом не может? А разве не опасны некоторые виды стафилококка, живущие на коже, и при выдавливании прыща на лбу, подбородке, или спине, вы подвергаете себя опасности распространению инфекции по всему организму через кровь и лимфу, потому что разрушили барьерную защиту в области прыща его выдавливанием? Не опасен ли стрептококк, который обитает в мочеполовой системе, но вы так увлеклись очищением-лечением себя от микоплазмы и уреаплазмы, которые вечно у вас находят, как не заметили, что из-за подавления защитных сил тонной ненужных и опасных препаратов у вас возникло серьезное воспаление почек из-за восходящей инфекции? Лечили больной зуб, а через две недели у человека воспаление внутренней стенки сердца – эндокардит.
Оказывается, многие наши микроскопические сожители при определенных обстоятельствах могут стать нашими злейшими врагами, и в состояние враждебности мы часто вводим их сами, потому что, стараясь тщательно избавиться от одного «страшного» микроба, мы убиваем наших друзей, которые помогают человеческому организму выполнять свою функцию правильно, или же обретаем в их лице врагов нашего здоровья. Как много из вас после лечения одних инфекций потом долго и печально пытались избавиться от грибковой инфекции? В кишечнике должны быть дрожжевые грибки, но не в том количестве, в котором они появляются после применения многих медикаментов. Создание порочного круга дисбаланса микрофлоры вашего организма и есть основная причина длительных инфекционных процессов, возникающих по очереди или вместе в разных органах и частях человеческого тела.
В отношении беременности и будущего ребенка, опасны многие возбудители, которые зачастую могут обитать в организме многие годы, начиная с раннего детства, и пожизненно – до глубокой старости. Большинство этих микроорганизмов вреда не приносят, но в период беременности, когда защитные силы организма понижаются (из-за того, что необходимо в течение девяти месяцев выносить ребенка – чужеродного агента для женского организма), некоторые инфекционные процессы могут активироваться, а также открываются ворота для нового вторжения других возбудителей. Хочется вас сразу успокоить, что не все так плохо и страшно, как это может показаться на первый взгляд, потому что население земного шара не уменьшается, а увеличивается в определенной прогрессии. Кроме того, самые высокие уровни рождаемости в весьма бедных экономически странах, где и уровни смертности не низкие. Это значит, что беременеть и вынашивать ребенка можно даже в самых худших условиях жизни, в том числе в условиях войны, в условиях антисанитарии, при отсутствии любой медицинской помощи. Конечно же, это не самый лучший или желаемый вариант для будущей матери. Но задумываясь над этими фактами, важно понять, что часто страхи, связанные с воспроизведением потомства, создаются искусственно, без научного обоснования, без учета статистики, и не без корыстной цели во многих случаях.
Поговорим о вирусах, так как их боятся больше всего. Хотя в переводе с латинского слово«вирус» означает «отрава» или «токсин», название такое весьма мрачное, однако не отражает миролюбивость большинства вирусов. Да, для размножения вирусам нужны живые клетки – как растительные, так и животные, что зависит от вида вируса. Однако, это не значит, что вирусы всегда разрушают эти клетки. Многие живут в клетках хозяина длительный период времени, не причиняя вреда, и эти клетки могут выполнять свою функцию нормально. В природе существует более 5 000 видов вирусов! А сколько видов еще не известны ученым? Вирусы находят и в холодных широтах Арктики и Антарктики, и в жарких влажных джунглях тропиков, и в горячих пустынях, и в глубинах океанов. Хотя известно такое большое количество видов вирусов, около 3 000 из них не изучены полностью, и даже не квалифицированы.
Вирусов, которые вызывают заболевания у людей, не так много. Многие вирусы весьма безопасны для человеческого организма. Хотя в процессе размножения вируса клетка-хозяин гибнет в большинстве случаев, на уровне огромного многоклеточного организма такая гибель не будет ощутимой. При гибели большего количества клеток появляются признаки вирусной инфекции.
Самыми распространенными являются вирусы, которые вызывают простудные заболевания (герпес, аденовирусы, ретровирусы, вирус ветрянки, вирус кори, цитомегаловирус, вирус Эпштейна-Барра и др.) Большинство людей заражается этими вирусами в раннем детстве и в школьном возрасте. Например, вспомните, разве у вас на губах не было высыпки пузырьков и не лихорадило хотя бы один раз в жизни?
Первый контакт вирусов с организмом человека называется первичным инфицированием, и в 90-95% случаев протекает незаметно для человека в отношении большинства вирусов. Реакция человеческого организма на попадание и внедрение вирусов весьма индивидуальна, и зависит от многих факторов, в том числе возраста человека. Обычно у детей первичное инфицирование проходит незаметно, в отличие от взрослых, особенно старших людей, реакция которых может быть весьма серьезной. Все, наверное, слышали, что куда легче перенести ветряную оспу в раннем детстве, чем будучи взрослым человеком.
После попадания в организм через входные ворота (а у каждого вида вируса свои входные ворота), происходит «путешествие» вирусов через кровь по всему организму человека, которое может длиться от нескольких часов до нескольких дней, а иногда и неделями. Опять же, большинство людей не ощущают этого. Первичное инфицирование любым вирусом может быть опасно для беременной женщины, особенно на ранних сроках беременности, так как, «путешествуя» по телу женщины, вирус может проникать через плаценту в организм эмбриона или плода, что может повлечь за собой его инфицирование, а также гибель. Однако, снова вас успокою, что в 90% случаев инфицирование плода большинством вирусов протекает без опасности для его здоровья и развития. Первичная инфекция опасна не так агрессивностью вирусов, а тем, что их большая порция может попадать в организм плода, так как защитные силы матери не успевают создать необходимый барьер.
Таким образом, когда мы говорим об опасности вирусных заболеваний для будущей матери и ее ребенка, в первую очередь мы говорим о случаях первичного инфицирования. При этом опасность могут представлять любые вирусы, а не только цитомегаловирусы или герпес-вирусы, которых так боятся женщины. Если эти вирусы обитают в вашем организме длительный период времени, в большинстве случаев такое состояние носительства для плода не опасно.
Пока вирусы «путешествуют» по организму, защитная система человека начинает вырабатывать огромное количество веществ, не позволяющих вирусам внедряться в клетки и поражать органы и системы органов. Одними из таких веществ являются антитела, или иммуноглобулины, так как это специфические белки. Сокращенное название антител – Ig. Одни виды антител находятся в крови и других жидкостях тела, и их основная задача — это связывание с чужеродными агентами – чужеродными телами (вирусами, например), что приводит к нейтрализации действия этого агента. Другая же группа антител прикрепляется к поверхности оболочки определенных клеток защитной системы, позволяя этим клеткам определить чужеродного внедрителя и создать больше антител и других веществ для их нейтрализации. Существует пять основных классов антител: IgA, IgD, IgE,IgG и IgM, по определению уровня которых можно определить состояние иммунной системы и активность инфекционного процесса. Антитела могут вырабатываться не только на чужеродные агенты, но и на собственные клетки организма, зачастую больные клетки, которые не могут выполнять свою функцию. На каждый агент вырабатываются специфические антитела, поэтому антитела от герпес-вируса не могут защитить человека от ВИЧ или других вирусов. Названия классов антител произошло от греческих литер, обозначающих специфику строения определенных частей молекул антител.
С точки зрения профилактики инфекционных процессов у беременных женщин, нас будут интересовать, в основном, только два класса антител IgG и IgM, уровень которых часто определяют в сыворотке крови, но мало кто из врачей интерпретирует результаты анализов правильно. Поэтому и назначается противовирусное лечение в тех случаях, когда оно не только бесполезно, но и опасно для женского организма.
При первичном контакте вируса, да и любого инфекционного агента, с человеческим организмом, защитная система начинает вырабатывать иммуноглобулины IgM. Эти антитела составляют от 5 до 10% всех антител человека. Уровень антител повышается в течение нескольких первых дней и недель, и обычно достигает вершины через 2-4 недели после инфицирования. Поэтому, если у вас обнаружили такой вид антител к какому-то возбудителю, важно повторить определение уровня антител в динамике, то есть через несколько дней. Если уровень растет, значит, ваше заражение (инфицирование) первично, что важно учитывать и, если существует возможность, предпринять меры против распространения инфекции и ее осложнений. Если у вас не выявлены такие антитела –радуйтесь! Это значит, что у вас не активной инфекции в организме, а значит лечение вам не показано.
Антитела IgM циркулируют в крови, являясь первым звеном ответной реакции организма на внедрение возбудителя, но они не могут проникать в ткани. В течение нескольких недель их уровень значительно понижается, и у большинства людей они исчезают из сыворотки крови через 2-6 месяцев после первичного инфицирования. Если у вас не находят такие антитела (на любой антиген), это значит что вы либо не инфицированы данным видом возбудителя (1), либо вы являетесь его носителем длительный период времени (2), у вас нет активного инфекционного процесса в организме (3).
На помощь и на смену IgM-антителам приходят антитела IgG, которые вырабатываются В-клетками, и они могут проникать в ткани человека, а также через плаценту в кровяное русло плода. От 75 до 80% всех антител, циркулирующих в организме человека, являются иммуноглобулинами IgG. Уровень этих антител начинает расти обычно с третьей недели инфицирования, достигает плато, то есть может быть высоким несколько недель, и потом понижается, иногда до уровней, когда определить наличие этих антител невозможно (зависит от вида возбудителя). Именно эти антитела характеризуют состояние вашей защитной системы, и являются положительным признаком того, что ваш организм хорошо справляется с инфекционным возбудителем. Опять же, определение только одного показателя уровня этих антител нецелесообразно. Лечение не должно назначаться при обнаружении только этого вида антител. Зачастую уровень IgG будет положительным для ряда инфекционных агентов у вас пожизненно, что является хорошим признаком, а не плохим.
Если говорить о защитной системе человека, то она чрезвычайно сложная и комплексная по строению и механизмам действия. Выработка антител – это всего лишь небольшое, но важное, звено этой системы. Ни в коем случае не нужно бояться наличия в вашем организме антител. Для будущего ребенка материнские IgG являются положительным признаком в отношении его защиты от многих инфекций.
Важно определение уровня антител не только в динамике, но и в их комплексе друг в другом. Что означают результаты, полученные в следующих комбинациях, где «-» –отсутствие антител (отрицательный результат), а «+» означает наличие антител, или положительный результат:
IgM -, IgG — – у вас никогда не было контакта с тем видом возбудителя, определение антител на который проводится в вашем случае. Желательно, чтобы вы привились от этого вида возбудителя, если существуют такие вакцины, или же вы должны избегать прямого контакта с людьми, которые являются носителями данного вида возбудителя. Такая комбинация также наблюдается для ряда инфекционных возбудителей, заражение которыми произошло очень давно, и, скорее всего, эти возбудители не присутствуют в вашем организме, а уничтожены защитной системой или же завершили свой жизненный цикл на уровне вашего организма.
IgM +, IgG — – вы, возможно, заразились этим возбудителем в течение последних 2-3 недель, поэтому необходимо повторить определение IgG через 1-2 недели. Иногда такой результат может быть лабораторной ошибкой.
IgM+, IgG+ – у вас первичное инфицирование, то есть, вы заразились данным видом возбудителя в течение последних 6 месяцев, или же произошла активация старой инфекции (даже при активации некоторых видов инфекции уровень IgM может быть отрицательным), поэтому необходимо провести ряд других диагностических тестов, определить уровни этих антител в динамике (через 1-2 недели).
IgM-, IgG + – такая комбинация наблюдается у большинства взрослых людей, что является показателем присутствия возбудителя в вашем организме (носительство). Для большего преимущества инфекций — это хороший показатель, характеризующий уровень вашей защитной системы. Такая комбинация наблюдается также после проведения прививок. Лечение в таких случаях не показано. Даже в случае опасных возбудителей (ВИЧ, вирус гепатитов В и С) проводят дополнительное обследование, для уточнения состояния процесса (активен, неактивен), потому что лечение в большинстве случаев будет неэффективным.
Определение комбинации антител к ряду возбудителей не должно проводиться поголовно у всего населения, а тем более, если человек уже является носителем тех инфекций, которые не опасны для его здоровья, или же он привит от данного заболевания. Перестраховка ради профилактики рецидивов и осложнений инфекции в большинстве случаев является лишней, нерациональной и даже вредной для здоровья человека.
Что происходит с вирусами после того, как они закончили свое путешествие по организму? Большинство из вирусов остается в организме человека пожизненно (пожизненно для вируса, пожизненно для человека). Они внедряются в те клетки, которые определяются их спецификой размножения, и могут там находиться довольно длительный период времени. Периодически они могут выходить из клетки, что называется процессом линьки для последующего размножения (деления). Чаще всего линька протекает бессимптомно, но в такие периоды люди могут заражать других людей этими вирусами. Опять же, такая картина характерна не для всех вирусов. В отношении ряда вирусов у ученых нет уверенности, остаются ли они в организме человека пожизненно, или же уничтожаются этим организмом (то есть, человек очищается от вирусов), так как антитела и ДНК или РНК вирусов в этих случаях не определяются (или же их уровень настолько низкий, что современные лабораторные технологии не позволяют их обнаружить).
Что важно помнить в отношении инфекции? Вы можете заразиться в любое время, даже за несколько дней до зачатия, а значит, отсутствие в вашем организме определенных возбудителей не гарантирует вам положительный исход вашей беременности. Поэтому большинство врачей утверждает, что носительство ряда инфекционных возбудителей (не всех, конечно) куда лучше, чем их отсутствие в организме. Почему? Потому что при контакте с больным человеком повторное заражение вам не грозит – у вас уже есть защита от этого вида возбудителя. Это не относится к бактериям и грибкам, где механизм защиты от этих микроорганизмов другой, поэтому многими бактериальными и грибковыми инфекциями вы можете заразиться несколько раз.
источник

Комментарии
Вставка изображения
Можете загрузить в текст картинку со своего компьютера: